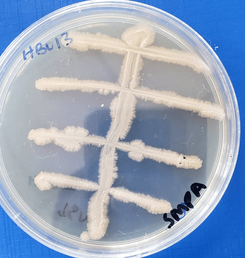

Cureus Journal of Medical Science
Environmental Health
LEARN MORE ABOUT CUREUS
Publishing in Cureus
Backed by Springer Nature, Cureus is a medical research journal that provides a smarter, more affordable, and hassle-free publishing experience. Learn more about the benefits of publishing with Cureus as well as how it all works!
Academic Channels
The subscription-based medical research publishing service that every academic department, medical school, and medical society needs. Create a branded destination showcasing your research and clinical experiences.
Article Collections
Cureus Collections present medical research articles by specific themes, simplifying the process of finding relevant research. We're not just curating science; we're curating the future of scientific exploration.
About Us
Cureus is dedicated to eliminating barriers to the generation and dissemination of medical knowledge. We’re leveraging the power of an online community platform to share and promote peer-reviewed medical research around the world.
BECOME A GUEST EDITOR
Shape the future of your field
Influence the trajectory of your specialty or area of expertise.
Drive community-centric selections
Play a pivotal role in guiding topic choices that resonate with our scientific community.
Curate cutting-edge research
Select, organize, and showcase articles on the most innovative topics in your specialty.
Enhance your professional profile
Leverage your role as a guest editor to add significant value to your CV. Highlight your leadership in steering innovative and diverse research directions.
Showcase depth and diversity
Use your expertise to demonstrate the breadth of exploration within your field.
CUREUS COLLECTIONS IN THE SPOTLIGHT
Browse >
Call for Articles
Guest Editor Collection